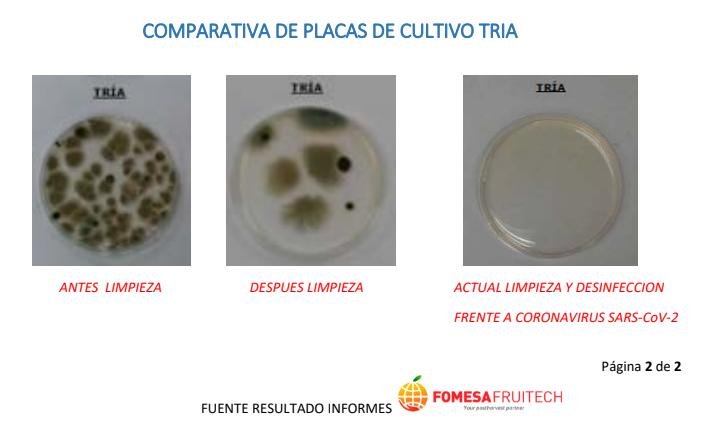

En momentos como el actual no podemos arriesgar porque son vidas lo que están en juego. Por eso, es importante realizar el proceso de desinfección de espacios de la forma más eficaz posible para que nos garantice la total eliminación del coronavirus COVID-19. Para conseguirlo, se convierte en una necesidad utilizar viricidas autorizados, destruyendo e inhibiendo así, la proliferación del virus.
A continuación, para comprender mejor la importancia de utilizar técnicas y productos adecuados, explicamos los resultados obtenidos en una industria alimentaria del sector de cítricos. El técnico de calidad ha implantado un plan de prevención y contingencia de coronavirus, y entre sus medidas incluye realizar desinfecciones periódicas. De esta forma, para conocer su eficacia, ha realizado diversos análisis de patógenos.
La validez de la siguiente información se sustenta sobre tres pilares fundamentales:
- Los análisis de patógenos han sido realizados por una empresa externa imparcial.
- Las tomas de muestras tuvieron lugar en puntos estratégicos de la industria, caracterizada por tener mucha carga de patógenos.
- ICSAM desconocía que se le estuviera haciendo un análisis de la eficacia de la desinfección, hasta que, desde la empresa, le hicieron llegar el informe.
En el informe aparecen tres escenarios (descarga aquí el informe completo):
- Análisis de patógenos antes de la limpieza.
- Análisis de patógenos después de realizar la limpieza habitual.
- Análisis de patógenos tras la limpieza y la desinfección realizada por ICSAM.
Resultado de nivel de patógenos antes y después de realizar la desinfección ICSAM
¿Las desinfecciones de espacios de coronavirus son efectivas?
El informe arroja unos resultados muy positivos, ya que después de la desinfección por parte de ICSAM, se han eliminado el 99,99 % de la carga biológica. Todo un éxito que demuestra que la técnica utilizada, junto a la profesionalidad y eficacia de nuestros técnicos de aplicación y con el producto biocida autorizado adecuado, se convierten en la solución perfecta para garantizar la erradicación y prevención total frente al virus COVID-19.
Desde ICSAM, hacemos mucho hincapié en la necesidad de contar con profesionales a la hora de realizar un tratamiento de desinfección por coronavirus. No solo porque el aplicador experimentado realiza una desinfección a fondo de todas las superficies, sino también porque controla las dosis y los tiempos de aplicación necesarios para un correcto uso, sin poner en peligro a seres humanos o animales.

Desinfección homologada coronavirus COVID-19 ICSAM
Actualmente, y gracias a la rápida difusión de todo tipo de noticias que desde varios Ayuntamientos han publicado en sus redes sociales, desde ICSAM hemos podido comprobar con gran preocupación, cómo una tarea tan delicada y precisa como es la desinfección de espacios y superficies de coronavirus se deja en manos de empresas del sector de la Sanidad Ambiental sin experiencia, y/o profesionalidad, realizando desinfecciones rápidas, ineficaces y sin tratar todas las superficies susceptibles de tener el coronavirus COVID-19.
Para terminar, resaltar que, a parte de las medidas preventivas de higiene y distanciamiento o de equipos de protección individual de los trabajadores que se están tomando desde la aparición del virus, va a ser necesario y obligatorio, por la salud de nuestros clientes, que empresas de todo tipo realicemos desinfecciones periódicas. En ICSAM llevamos a cabo desinfecciones para eliminar el coronavirus en las provincias de Valencia, Alicante y Castellón. Utilizamos viricidas autorizados para conseguir que cada centro de trabajo vuelva a resultar seguro, y corregir así el error humano que ha provocado que lleguemos a una situación como la actual (mal uso de EPIs, incompleta limpieza de las instalaciones, etc).

Comentarios recientes